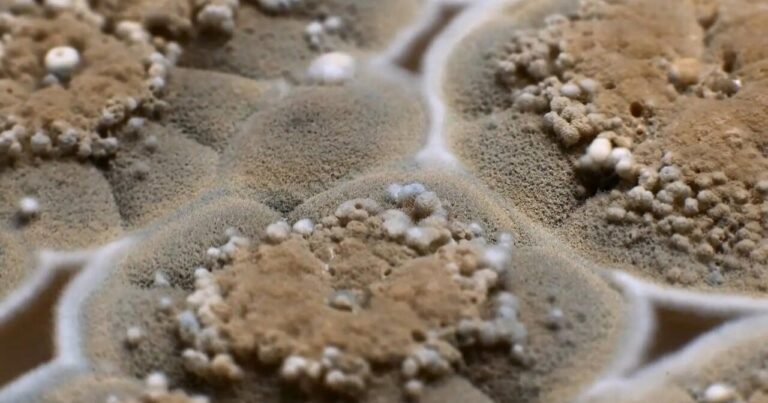
Evdə nəmlik və kifə qarşı 7 effektli bitki – Ekspert məsləhəti ilə Evdə nəmlik və kifə qarşı 7 effektli bitki – Ekspert məsləhəti ilə

Ev şəraitində toplanan nəmlik zamanla küfün yaranmasına və xoşagəlməz qoxulara yol açır. Bu problemi yalnız dezinfeksiya və havalandırma ilə həll etmək çətin ola bilər. Mütəxəssislər bildirirlər ki, düzgün seçilmiş ev bitkiləri dekorasiyadan başqa, nəmi tarazlayaraq havanı təbii şəkildə “süzə” və daha sağlam bir mühit yarada bilər.
KONKRET.az milliaz-a istinadən xəbər verir ki, “Greenways Nursery”nin bitki mütəxəssisləri, aşağıdakı 7 bitkinin nəm tarazlığında və hava keyfiyyətinin yaxşılaşmasında təsirli olduğunu vurğulayırlar.
Ev üçün tövsiyə olunan 7 bitki
Yaşıl Qərərtiotu
Bu firuzəyi frondlu bitki xüsusilə nəmlikli yerlərdə, məsələn hamamda və mətbəxdə, havadakı artıq su buxarını udur. Mütəxəssislər hesab edirlər ki, onun incə yarpaqları kondensasiyanı azaltmağa yardım edir.
Esparraguera
Telkari, incə görünüşlü gövdəsi ilə diqqət çəkir və yüksək nəmli mühitlərdə nəmi effektli şəkildə çəkərək hava keyfiyyətini yaxşılaşdırır.
Yaşıl Zambak
Baxımı asandır və dəyişkən nəmlik şəraitinə davamlıdır. Ev havasını təravətləndirərək küf riskini azalda bilər.
Barış Zambağı
Təbii hava filtri kimi işləyir: yarpaqları vasitəsilə nəmi udur və hava çirkləri (məsələn, küf sporları) ilə mübarizə aparır. Bu bitki, Homes & Gardens portalında kondensasiya və küfün qarşısını almaq üçün ideal seçim kimi tövsiyə olunur.
Sarmaşık
Havada dolaşan küf sporlarını ala bilən bu sarmaşık növü həm dekorativdir, həm də nəm udma xüsusiyyətinə malikdir.
Sansevieria
“Anaipləyənin dili” kimi tanınan bu bitki gecə vaxtı belə oksigen buraxır və nəmli hava şəraitində belə davamlıdır. Greenways Nursery onu nəm tarazlığı üçün tövsiyə edir.
Home and Gardening Ideas
Parlaq rəngli çiçəkləri ilə estetik yönü güclüdür və eyni zamanda mühitdəki artıq nəmi tarazlaşdırmağa kömək edir.
Bitki mütəxəssisi Angela Slater bildirir ki, “Barış Zambağı (Peace Lily) yüksək nəmlikli otaqlarda, xüsusilə hamamda və mətbəxdə, nəmi yarpaqları ilə udur və kondensasiya ilə mübarizə aparır. Böyük ölçülü saksı daha səmərəli işləyir”.
Slater həmçinin xəbərdarlıq edir ki, bu bitki ev heyvanları üçün toksik ola bilər, buna görə ev heyvanlarının çata bilmədiyi yerdə saxlanmalıdır.
Mütəxəssislərin tövsiyə etdiyi bu yeddi bitki yalnız estetik dəyər daşımır, eyni zamanda evdə nəmliyi tarazlamağa və küfün yaranmasını önləməyə kömək edir. Lakin, unutmaq olmaz ki, bitkilər tam “qurtarıcı” deyildir, havalandırma, düzgün izolasiya və nəzarətli suvarma kimi tədbirlər hələ də vacibdir.